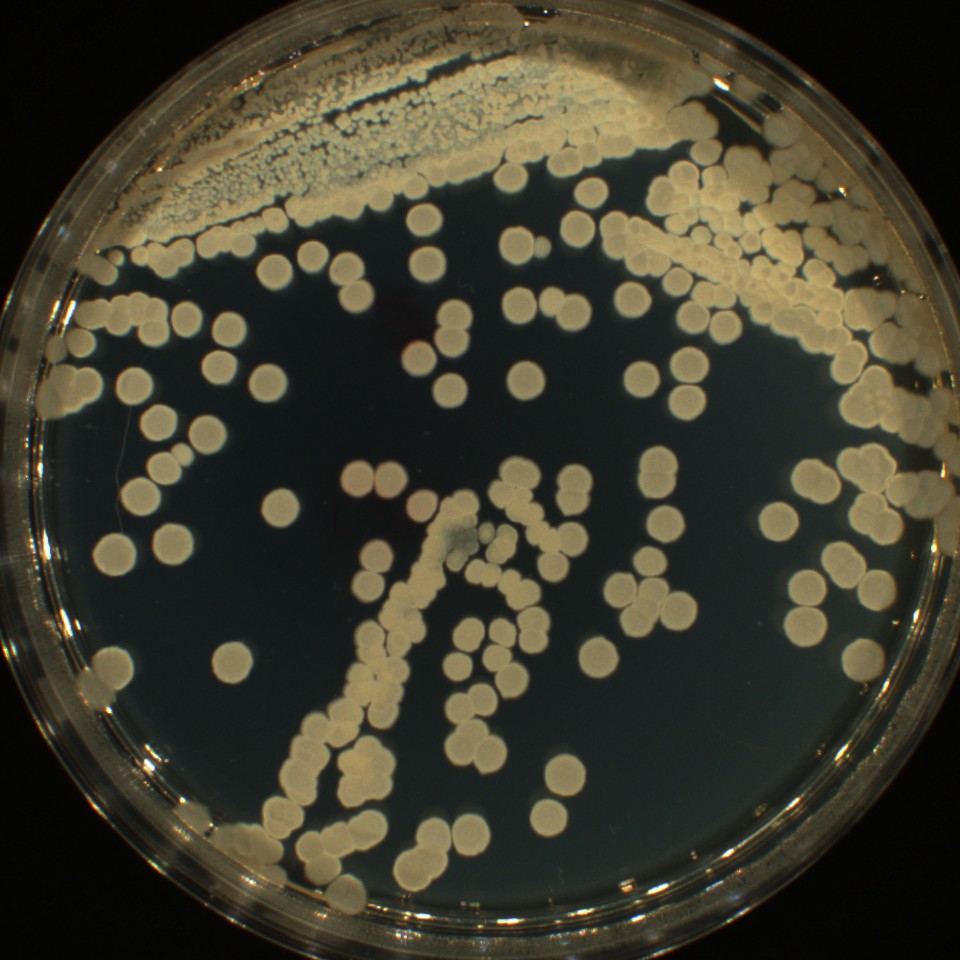

Ghost Orchid
On this page
Research
Process
Installation
Installation



Works included
Year
Team
Tamara Pilawska Baranowska
Igor Jansen
Jakub Kozlowski
Gosia Hinz
Klara Czerniewska-Andryszczyk
Micaela Costa
Adam Białek
Marcjana Wojdyła
Jacqueline Sobiszewski
Luke Jaszcz
Marcel Kaczmarek
Specialists
Małgorzata Stpiczyńska, Botanical Garden of the Polish Academy of Sciences, Warsaw
Bogusław Binkiewicz, Botanical Garden of the Jagiellonian University, Krakow
Project co-financed by the Minister of Culture and National Heritage of the Republic of Poland (iam.pl)
The POL-KOMP product was created as part of the project ‘Bioproduct accelerating the decomposition of biodegradable polymeric materials in compost’ (no. LIDER/48/0247/L-12/20/NCBR/2021) financed by the National Centre for Research and Development (NCBR).
Photo credits
Marcin Rusak Studio
Rusak Family Archive
Exhibitions / Location
Milan, Italy
Świdno, Poland
Tamara Pilawska Baranowska
Igor Jansen
Jakub Kozlowski
Gosia Hinz
Klara Czerniewska-Andryszczyk
Micaela Costa
Adam Białek
Marcjana Wojdyła
Jacqueline Sobiszewski
Luke Jaszcz
Marcel Kaczmarek
Małgorzata Stpiczyńska, Botanical Garden of the Polish Academy of Sciences, Warsaw
Bogusław Binkiewicz, Botanical Garden of the Jagiellonian University, Krakow
Project co-financed by the Minister of Culture and National Heritage of the Republic of Poland (iam.pl)
The POL-KOMP product was created as part of the project ‘Bioproduct accelerating the decomposition of biodegradable polymeric materials in compost’ (no. LIDER/48/0247/L-12/20/NCBR/2021) financed by the National Centre for Research and Development (NCBR).